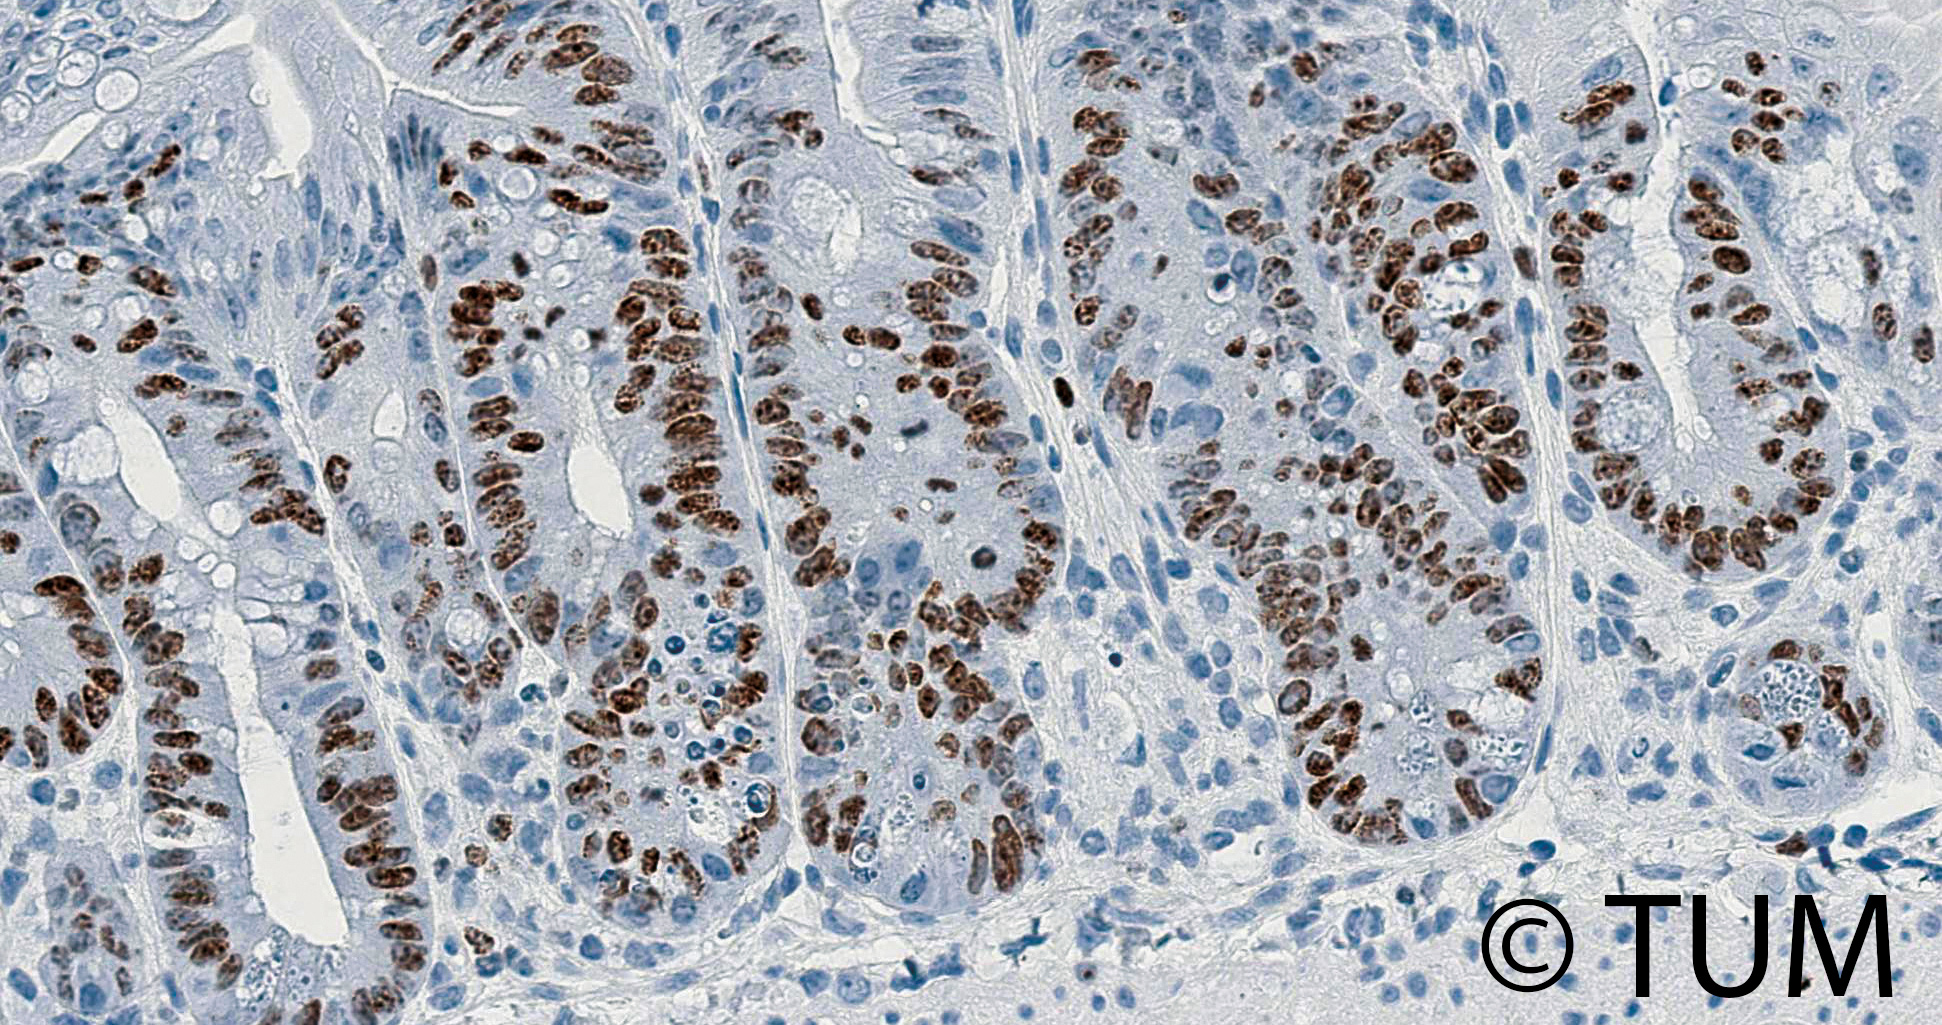
Mikroskopische Aufnahme von Darmepithel zeigt zahlreich braun gefärbte, proliferierende Zellen in den Kryptenstrukturen.

Das Darmgewebe nimmt häufig Schaden, wenn Krebspatienten eine Chemo- oder Immuntherapie erhalten oder sich einer Bestrahlung des Bauchraums unterziehen müssen (Abb. 1).
Abb. 1 Proliferierende Epithelzellen (braun markiert) im Darm eine Woche nach einer Bestrahlung des Bauchraums.
Ursächlich sind neben einer direkten zytotoxischen Wirkung auf Epithel- und Stromazellen auch indirekte immunologische Mechanismen. Die gastrointestinale Toxizität ist deshalb ein dosislimitierender Faktor von Krebstherapien, weshalb Forschende der Klinik und Poliklinik für RadioOnkologie und Strahlentherapie der TU München nach einem Weg suchen, das Darmepithel zu regenerieren. Im Fokus ihrer Forschung stehen regulatorische T-Zellen (Treg): Diese unterstützen neben ihren immunsuppressiven Funktionen auch die Reparatur des Darmgewebes. Denn sowohl im Mausmodell als auch in Patientenproben konnten die Forschenden nachweisen, dass Treg die Entzündungssignale Interferon-gamma (IFNγ) und Interleukin-10 (IL-10) abgeben. Diese fördern gemeinschaftlich intestinale Stammzellen, die sowohl zu einer Heilung als auch zu einer langfristigen Regeneration des Darms nach immun- und strahlungsbedingten Schäden führen [Fischer JC et al. Signal Transduct Target Ther. 2025;10(1):384]. Das Forschungsteam arbeitet nun daran, neue therapeutische Ansätze zur Förderung der Darmreparatur zu entwickeln.
Sabrina Kempe